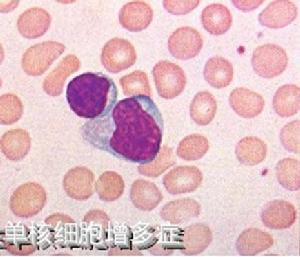

传染性单核细胞增多症是由EB病毒(EBV)感染所导致的急性感染性疾病,主要发生在儿童和青少年,临床上以发热、咽喉痛、肝脾和淋巴结肿大、外周血中淋巴细胞增多并出现单核样异型淋巴细胞等为特征。

Ø 传染性单核细胞增多症症状和表现:
发热:体温38-40℃,热程大多1~2周,少数可达数月。
咽峡炎:大多数患儿表现为咽炎、扁桃体炎、腭垂充血、肿胀,可见出血点,伴有咽痛。部分患儿扁桃体表面可见白色渗出物或假膜形成。咽部肿胀明显者可出现呼吸和吞咽困难。
淋巴结肿大:全身淋巴结均可肿大,以颈部最为常见(1cm以上)。
肝脾肿大:约占20%~62%,大多数在肋下2cm以内,可出现肝功能异常。
皮疹:部分患者出现多形性皮疹。
Ø 传染性单核细胞增多症的治疗:
1. 对症治疗:急性期卧床休息,高热患儿可用退热剂降温。咽痛者可用生理盐水漱口或含片含服。
2. 抗病毒治疗:阿昔洛韦、更昔洛韦及伐昔洛韦等药物。
3. 若继发细菌感染,给予抗生素。
4. 丙种球蛋白:改善临床症状,缩短病程,早期给药效果好。
Ø 传染性单核细胞增多症的注意事项:
1. 肝脾肿大患儿卧床休息,避免剧烈活动。
2. 体温过高时予药物降温,患儿出汗较多时应及时补充水、电解质,并作好口腔护理。
3. 患儿因咽部肿胀、疼痛不愿进食,应鼓励患儿少食多餐,进食高热量、高蛋白、清淡、易消化食物。逐渐增加粗纤维食物,确保大便通畅。
参考文献:
[1]张琳琪.实用儿科护理学.第1版.北京:人民卫生出版社,2018.
[2]王卫平.儿科学.第9版.北京:人民卫生出版社,2018.
修订时间:2022.04
修订人:叶娟
审核人:蒋丽琼


